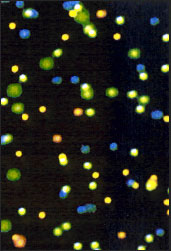
molesc

Juvenile coho salmon
(Oncorhynchus kisutch)
Juvenile coho salmon
(left) under UV light
Scroll down to see more images.
Jean Krejca, Univ. of Texas marking blind cave fish with BMX1000 PEN-JECT (Courtesy of J. Krejca)
Blind cave fish (Anoptichthys
jordani) Courtesy of J. Krejca.
Juvenile steelhead trout
(O.mykiss)
Juvenile steelhead trout
(left) under UV light
Adult brook trout (Salvelinus fontinalis)
Coutesy of Alan Hemmingsen,
Oregon Dept. of Fish & Wildlife
Adult river chub (Nocomis microposon)
Courtesy of Brett Albanese
Virginia Tech. University
Adult walleyes (Stizostedion vitreum)
Courtesy of Philip Rieger
Mead & Hunt, Inc.
Sample microspheres of BPTs magnified and photographed under UV light.
Electron micrographic examination of cryptic BPT microspheres (without UV light) 36 months after marking in a fin of rainbow trout (oncorhynchus mykiss).
Courtesy of the University of California at Davis, Bodega Marine Laboratory
Adult Chinese mitten crab
(Eriocheir sinens)
Juvenile blue gill (Lepomis macrochirus)